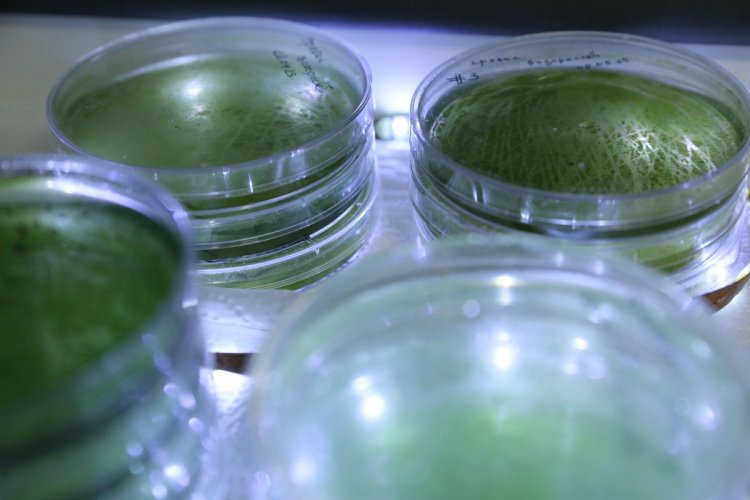

Как работает память? Чем нейробиологов привлекают живые реликты — микроскопические животные трихоплаксы? Почему наш мозг не может одновременно задействовать 100% своих «мощностей»? Как развивалась нервная система живых существ в процессе эволюции? Об этом и многом другом узнали в Институте высшей нервной деятельности и нейрофизиологии РАН участники студенческого тура, проведенного «Научной Россией» 10 октября.
Эволюционная нейробиология и «кухня» памяти
ИВНД и НФ РАН — флагман академии наук в области физиологии человека и животных. Сегодня здесь работают 17 лабораторий. Одна из них фокусируется на клеточной нейробиологии обучения. Сотрудники этой лаборатории стремятся проникнуть в глубинные механизмы памяти и поведения на клеточном и молекулярном уровнях. Именно здесь побывали гости института во время тура, проведенного нашим порталом.
Одно из направлений исследований лаборатории — изучение эволюции нервной системы как структуры живых организмов. Это молодая, но очень важная область.
Участники студенческого тура «Научной России» с сотрудниками лаборатории клеточной нейробиологии обучения ИВНД и НФ РАН.
Фото: Николай Малахин / «Научная Россия»
«Мое поле деятельности — эволюционная нейробиология. <…> Сегодня исследования мозга сталкиваются с существенной проблемой, поскольку он огромен, в него входит очень большое количество нейрональных и глиальных клеток. <…> Главная сложность состоит в том, чтобы объединить все знания о нашем мозге <…>: при этом важно учитывать не только физиологию, оценку поведенческих реакций человека, но и то, как все эти процессы реализуются на клеточном уровне и каким образом с ними связана работа молекулярно-генетического аппарата. Это поможет ответить на вопросы, которые очень интересуют ученых: как работает наш мозг, что представляет собой память и, самое главное, что такое сознание? Пока мы не изучим работу нервной системы во всех деталях на клеточном и молекулярном уровнях, мы не сможем это узнать. Именно для этих целей появилось очень перспективное направление эволюционной нейробиологии. Оно направлено на то, чтобы понять, как наш мозг начал формироваться с течением эволюции, потому что он возник не “по щелчку пальцев”. Эволюционные этапы, на которых появлялись различные мозговые структуры <…>, происходили не одномоментно. <…> Чтобы понять, как работает наш мозг, нужно выяснить, для чего были созданы его отдельные структурные элементы», — объяснила научный сотрудник лаборатории клеточной нейробиологии обучения ИВНД и НФ РАН кандидат биологических наук Дарья Юрьевна Романова.
Исследователь рассказала студентам о сущности памяти — ее эволюционных преимуществах и глубинных механизмах работы.
Научный сотрудник лаборатории клеточной нейробиологии обучения ИВНД и НФ РАН кандидат биологических наук Дарья Юрьевна Романова.
Фото: Николай Малахин / «Научная Россия»
«В контексте эволюции память — это сохранение ресурса. Это касается не только человека, но и животных. Допустим, чтобы находить места с хорошей кормовой базой, зверь должен запоминать, где он увидел более зеленую траву. Другой пример — уход от угрозы. Наша реакция избегания опасности очень негативно окрашена именно для того, чтобы максимально остро отложиться в нашей памяти. В следующий раз это должно помочь нам избежать конкретных действий, людей, ситуаций — среагировать на опережение, чтобы не столкнуться с угрозой снова», — сказала Д.Ю. Романова.
С точки зрения эволюции, механизм запоминания дает возможность нервным клеткам более эффективно расходовать энергию. И это важно, учитывая, что на передачу каждого сигнала между нейронами уходит огромное количество энергии, при этом 70% от нее нейроны тратят на восстановление после проведения нервного импульса. Кстати, именно с этим связан популярный миф о том, что мозг человека не задействует свой полный потенциал. Во время «отдыха» после передачи сигнала нервные клетки временно отключаются от процесса проведения импульсов, и их функции берут на себя другие нейроны. Поэтому с точки зрения расхода энергии наш мозг действительно не может задействовать 100% своих «мощностей» одномоментно: какая-то часть его нейронов все равно будет «отдыхать».
На биохимическом уровне формирование воспоминаний, передача информации между нервными клетками — сложный процесс, напоминающий конструктор из множества деталей. С некоторыми из таких «паззлов» Дарья Юрьевна познакомила гостей института. Исследовательница рассказала о глутамате — одной из основных молекул, участвующих в передаче нервного импульса. Интересно, что производное глутамата — гамма-аминомасляная кислота — связано с иммунной системой. Есть предположения, что именно поэтому при стрессе люди начинают чаще болеть. Сейчас ученые пробуют подтвердить это экспериментально.
Участники студенческого тура «Научной России».
Фото: Николай Малахин / «Научная Россия»
Примечательный «кирпичик» памяти на клеточном и молекулярном уровнях — липидные рафты — особые структуры на мембране нервных клеток, играющие важную роль в передаче импульса между нейронами. Именно в липидных рафтах находятся рецепторы, захватывающие молекулы глутамата, которые, в свою очередь, запускают каскад химических реакций, позволяющих провести сигнал между клетками.
«В прошлом считалось, что все процессы в нашем мозге обеспечиваются только ядром нервной клетки, работой определенных генов. Но неожиданно оказалось, что во всем этом участвуют не только гены, но и <…> липиды, способные выступать критически важным структурным элементом мембраны нейронов», — подчеркнула Д.Ю. Романова.
Глутаматные рецепторы — один из ярких примеров усложнения нервной системы в процессе эволюции. У одноклеточных животных и растений (например, у архей и золотистых водорослей) они состоят всего из двух структурных доменов и отвечают за ориентацию в пространстве с помощью хеморецепции (восприятия химических стимулов). А у многоклеточных организмов (например, гребневика) все те же рецепторы включают уже три домена и участвуют в процессе передачи информации. Причем у особенно «высокоуровневых» существ (например, у крыс) к классической трехдоменной структуре еще добавляются фрагменты, которые, как предполагают ученые, связаны с иммунными процессами.
«В ходе эволюции мы наблюдаем движение от простого к сложному. Сначала мы имели очень простые реакции и функции, но чем сложнее организм, тем сложнее становятся и рецепторы. В принципе, это можно считать особенностью эволюции в целом, — сказала Д.Ю. Романова. — Гены на самом деле не элиминируются, потому что, если мы вернемся к вопросу энергоэффективности, гораздо проще изменить функцию гена или дать ему дополнительную функцию “в нагрузку”, чем вырезать его из генома».
В гостях у трихоплаксов
Удивительные животные, позволяющие ученым вернуться к самым истокам эволюции нервной системы, — трихоплаксы. Эти многоклеточные создания выглядят как крошечные плоские капельки и обитают на Земле уже как минимум полмиллиарда лет. Несмотря на отсутствие нервной системы, трихоплаксы обладают сложным поведением — в этом им помогает межклеточная коммуникация с помощью сигнальных молекул. Изучение этих процессов помогает ученым лучше понять, как в организме происходит передача информации на химическом уровне, что, в свою очередь, обогащает знания об эволюции и работе нервной системы живых существ в целом, включая человека.
«Мы считаем, что у трихоплакса настолько сбалансированная физиология, что у него не появилась нервная система попросту потому, что она ему не нужна. <…> Это животное стало для науки ключом к пониманию, как появились мозг и нейрон и каким образом они работают», — поделилась Д.Ю. Романова. Ее команда — крупнейшая в России научная группа (и одна из немногих в мире), занимающаяся изучением трихоплаксов. Исследования проводятся по проекту Российского научного фонда «Геномные и клеточные основы поведения у безнервных животных».
Сотрудник лаборатории клеточной нейробиологии обучения ИВНД и НФ РАН, аспирант Александр Алексеевич Повернов показывает студентам культуры трихоплаксов, выращиваемые в институте.
Фото: Николай Малахин / «Научная Россия»
Сегодня работа с трихоплаксами обогащает фундаментальную науку, но в перспективе она может принести большую практическую пользу. Так, эксперименты с рецепторами древних животных могут помочь найти новые обезболивающие вещества. А в отдаленном будущем глубинное понимание биохимических основ передачи информации может даже позволить создать искусственный мозг.
Дарья Юрьевна рассказала о сложном поведении трихоплаксов в разных ситуациях, наблюдавшемся ее научной группой. Эти животные по-разному реагируют на свет: при очень ярком освещении сворачиваются либо пытаются отдалиться от неприятного стимула, а при тусклом, наоборот, стремятся приблизиться к источнику освещения. Получив повреждение, трихоплакс не только стремительно съеживается, чтобы закрыть раневую поверхность, но и довольно быстро уползает в противоположную сторону от травмировавшего его предмета. Животное активно сворачивается в ответ на механическое воздействие, такое как поддув воды. Интересный эксперимент провели ученые из Стэнфордского университета, выяснив, что трихоплаксы очень чувствительны к температуре: они всегда перемещаются из более холодных мест в более теплые даже при незначительном перепаде. Еще один пример сложного поведения трихоплаксов — хорошая ориентация в пространстве.
«Среди десяти клеточных типов трихоплаксов есть гравитационные сенсоры. Благодаря им, если мы подхватим животное микропипеткой и пересадим в другую чашку Петри, особь “расправится” и сядет на субстрат только нижней стороной вне зависимости от того, под каким углом мы ее пересадили: 90°, 45° и т.д.», — отметила Д.Ю. Романова.
Студенты получили возможность понаблюдать за трихоплаксами через микроскоп.
Фото: Николай Малахин / «Научная Россия»
Примечательны и другие сложные реакции трихоплаксов. Например, при обилии пищи эти животные не отстраняются друг от друга после деления, а продолжают держаться в группах — коллективно они могут перерабатывать больше питательного субстрата. А чтобы защититься от «взбунтовавшихся» внутренних бактерий, животное заключает их в особую сферу и выбрасывает из организма. Подробнее об этом можно прочитать в ранее опубликованной новости «Научной России».
Участники студенческого тура побывали «в гостях» у необычных реликтов. Животные обитают в чашках Петри в искусственной морской воде на питательном субстрате. Трихоплаксы весьма капризны, поэтому в климатостате, где размещаются культуры, постоянно поддерживаются комфортные условия — дневной и ночной световой режимы, температура около 23°C и высокая влажность.
Культуры водорослей для питания трихоплаксов.
Фото: Николай Малахин / «Научная Россия»
«На данный момент у нас хранятся около 50 чашек, несколько линий. В частности, у нас есть нормальная линия — животные на зеленых водорослях <…>. Имеется также ампициллиновая культура — трихоплаксы, к которым мы добавляем антибиотик ампициллин, подавляющий рост внутриклеточных паразитов. Благодаря антибиотикам у этой линии отличается культуральная динамика: такие животные медленнее увеличиваются в числе, но при этом более устойчивы к внешним воздействиям. Когда в чашке Петри накапливается много вредных веществ, животные обычной линии начинают погибать, в то время как ампициллиновая линия может прожить на несколько месяцев дольше. Мы также выращиваем рисовую линию: вместо водорослей, полностью покрывающих дно, в чашках этих особей располагаются по несколько рисовых зернышек, выделяющих в воду питательные вещества. У этой линии очень сильно отличается культуральная динамика: такие особи размножаются в несколько раз быстрее: когда в нормальной чашке число животных достигает около 80–100, в рисовой может находиться уже 200–300 особей. Но этот прирост очень быстро прекращается, и уже примерно через одну-две недели количество трихоплаксов идет на спад и уменьшается до 20–30. Тогда мы пересаживаем животных в новую чашку и опять наблюдаем быстрый рост. Насколько мы знаем, животные нормальной, рисовой и ампициллиновой линий немного отличаются друг от друга <…>, поэтому для некоторых исследований можно брать особей только одной линии или изучать представителей разных культур с точки зрения их различий», — объяснил сотрудник лаборатории клеточной нейробиологии обучения, аспирант Александр Алексеевич Повернов. Ученые также ведут работу с культурами отдельных клеток, выделенных из тел трихоплаксов.
Размеры трихоплаксов заметно варьируются: от 30 мк до 2 мм. Студенты получили возможность увидеть их в 50-кратном увеличении в мощный микроскоп: молодым людям даже повезло наблюдать процесс вегетативного деления одной из особей.
Как рассказала Д.Ю. Романова, чтобы упростить изучение строения таких небольших созданий, их команда применила метод экспансивной (расширительной) микроскопии. В результате специальной обработки образец организма как бы «разбухает», позволяя более детально рассмотреть его мельчайшие внутренние структуры. Сам подход использовался в науке и ранее, но тела трихоплаксов таким образом увеличили впервые: подробнее об этом можно узнать в ранее опубликованном материале на нашем портале.
От генома к поведению
В заключение тура студенты узнали о геномных исследованиях трихоплаксов, ведущихся в институте, и увидели секвенатор, который ученые используют для анализа. Сам высокотехнологичный прибор, куда погружаются образцы, очень компактен, а за сложные вычисления отвечает подсоединенный к системе мощный компьютер. Преимущество используемого в институте секвенатора — в возможности анализировать очень длинные фрагменты ДНК, что позволяет получить высококачественные результаты.
Как рассказала Д.Ю. Романова, для секвенирования из образцов в стерильных условиях готовится специальная суспензия. Затем она наносится на чипы, которые вставляются в секвенатор. Процесс анализа генома занимает 72 часа.
Трихоплаксы — древние многоклеточные животные. Для нейробиологов они интересны тем, что демонстрируют сложное поведение, несмотря на отсутствие нервной системы.
Фото: Николай Малахин / «Научная Россия»
«Год назад мы отсеквенировали геном наших трихоплаксов, получив около 90 гигабаз данных (1 гигабаза — миллиард пар нуклеотидов — Примеч. корр.). Это очень хороший результат. <…> Одна из статей, над которыми мы работаем, как раз посвящена тому, что мы подготовили очень детальный анализ генома и характеристику хромосом», — объяснила Д.Ю. Романова.
Сбор образцов для анализа занял около двух месяцев. С такой высокой точностью геном трихоплакса был расшифрован впервые.
Полное погружение в науку: гости института получили возможность задать вопросы исследователям.
Фото: Николай Малахин / «Научная Россия»
С течением времени в геноме трихоплаксов, как и любых живых существ, накапливаются мутации. Поэтому исследователи хотят повторить анализ генетической информации животных через пять и десять лет, чтобы отследить возможные изменения. А в самое ближайшее время на секвенаторе планируется провести немного другие изыскания, посвященные транскриптомной активности трихоплаксов.
«Мы хотим посмотреть, как работают гены наших животных в разных условиях. Это также будет связано с поведенческим анализом <…>. Мы посмотрим, как реализуется поведение трихоплаксов и как это выглядит на уровне работы генома», — пояснила Д.Ю. Романова.
Материал подготовлен при поддержке Министерства науки и высшего образования РФ